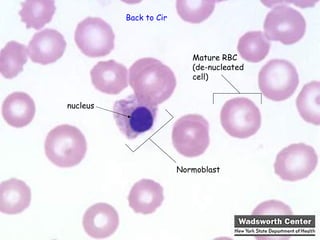
Back to Circulatory System




                          Mature RBC
                          (de-nucleated
                          cell)


nucleus




                      Normoblast
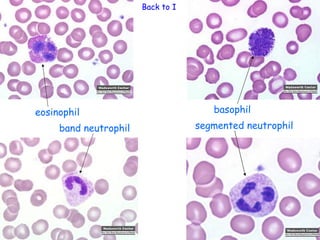
Back to Immune System




eosinophil                             basophil
     band neutrophil               segmented neutrophil

This document provides a table of contents and overview of organ systems, organs, and tissues of the human body. It includes sections on the digestive system, circulatory system, respiratory system, immune system, skin, urinary system, endocrine system, reproductive system, nervous system, and dense connective tissue systems. Each section provides subsections and images related to the major components. The document aims to provide a comprehensive overview of human anatomy through detailed sections and diagrams.